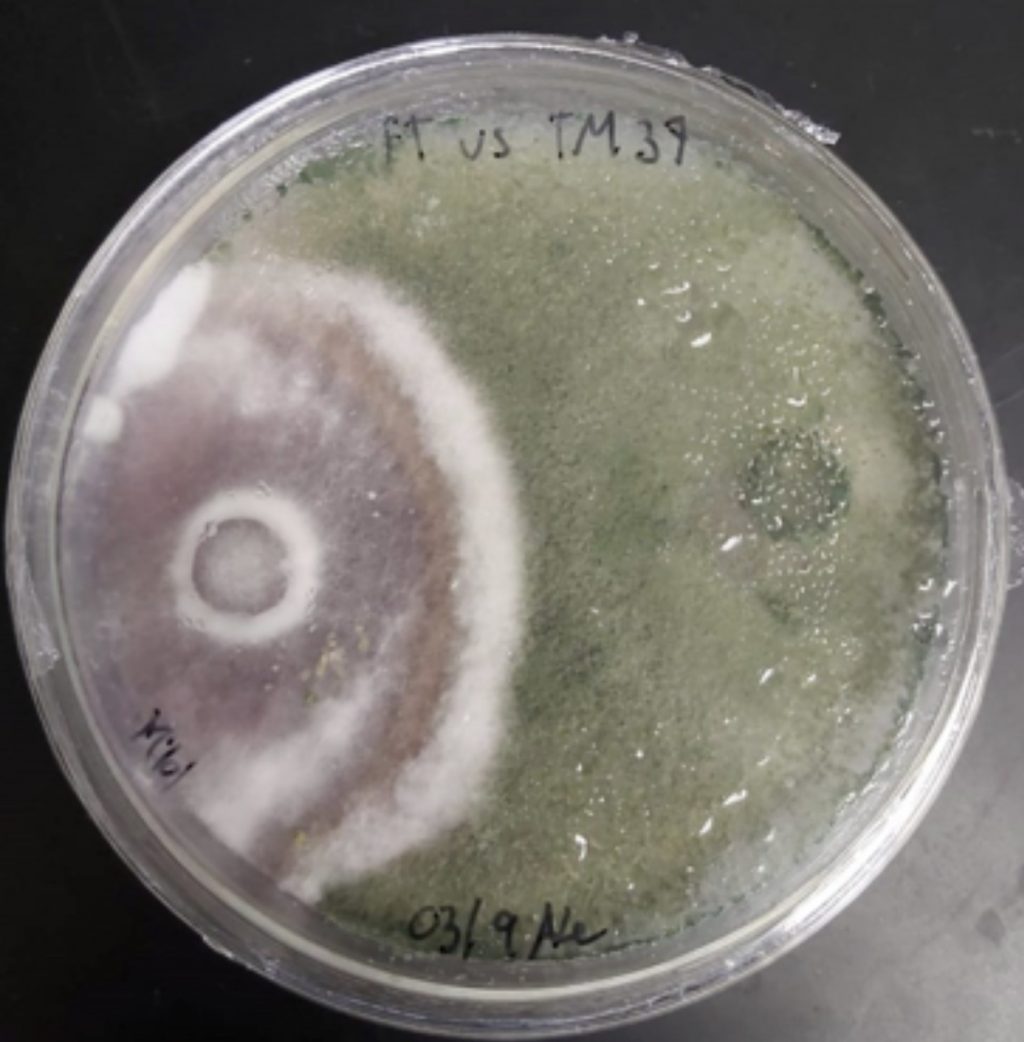

Fuzarioza tomatelor, denumită și ofilirea vasculară, este o boală fungică provocată de Fusarium oxysporum. Deși nu se numără printre cele mai frecvente boli ale tomatelor, este extrem de dăunătoare atunci când afectează cultura.
Ce este fuzarioza și cum se transmite
Fuzarioza este cauzată de ciuperca Fusarium oxysporum, care trăiește pe resturile vegetale și în sol, la adâncimi de până la 80 cm, unde rezistă ani întregi.
Infecția apare prin sol contaminat, semințe nedezinfectate, resturi vegetale și unelte murdare. Ciuperca pătrunde în plante prin răni produse la transplantare, tăierea frunzelor sau prin mușcături de insecte.
Răspândirea sporilor este favorizată de vânt, insecte, păsări, umiditatea ridicată și lipsa rotației culturilor.
Tomatele pot fi infectate în orice stadiu de dezvoltare, dar cel mai des în a doua jumătate a sezonului, când temperatura (27-28°C) și umiditatea sunt optime.
Simptome distinctive
Primele semne de fuzarioză pot fi confundate cu lipsa apei: frunzele se ofilesc și își pierd turgescența. Ulterior, frunzele se răsucesc, devin galbene (de la bază spre vârf) și apar țesuturi necrotice între nervuri.
Ofilirea poate afecta doar o parte a plantei, deoarece ciuperca circulă prin sistemul vascular. La secționarea tulpinii, țesuturile interioare devin maro deschis, iar baza rădăcinii poate prezenta un inel roz.
Fuzarioza la tomate – factori favorizanți
Dezvoltarea fuzariozei este favorizată de:
- umiditate ridicată,
- lipsa rotației culturilor,
- sol acid și nisipos,
- ventilație slabă în sere, solariu,
- schimbări bruște de temperatură,
- prezența buruienilor și a resturilor vegetale.
Prevenirea bolii
Măsurile preventive sunt cele mai importante în controlul fuzariozei, printre care:
- respectarea rotației culturilor
- strângerea și distrugerea reziduurilor vegetale (sursă de infecție pentru următorul sezon)
- combaterea buruienilor
- dezinfectarea solului, a uneltelor
- tratarea semințelor și plantarea doar a răsadurilor sănătoase
- utilizarea varietăților rezistente la fuzarioză
- îmbunătățirea solului prin aplicarea îngrășămintelor cu calciu, pentru solurile acide și sărate.
Colonizarea solului cu bacterii benefice (bacili de fân, trichoderma) contribuie la combaterea naturală a patogenului, deoarece aceste microorganisme concurează cu Fusarium și limitează dezvoltarea ciupercii.
Combaterea fuzariozei
Tratamentul curativ al fuzariozei este dificil. În cazul apariției bolii, plantele afectate trebuie eliminate și distruse, iar solul tratat cu fungicide.
Produsele pe bază de dazomet, cum ar fi Basamid Granule, pot fi aplicate la sol, înainte de plantare, pentru prevenirea infecției. În stadii incipiente, se pot utiliza bactericide pe bază de Bacillus subtilis.
În plus, pot fi aplicate produse pe bază de hidroxiquinoleina și fertilizanți cu fosfot și potasiu pentru a spori rezistența plantei.
Remediile populare (se încearcă frecvent soluții din lapte și iod sau infuzie de coajă de ceapă) nu sunt eficiente, deoarece ciuperca a ajuns în sistemul vascular.

Comentarii